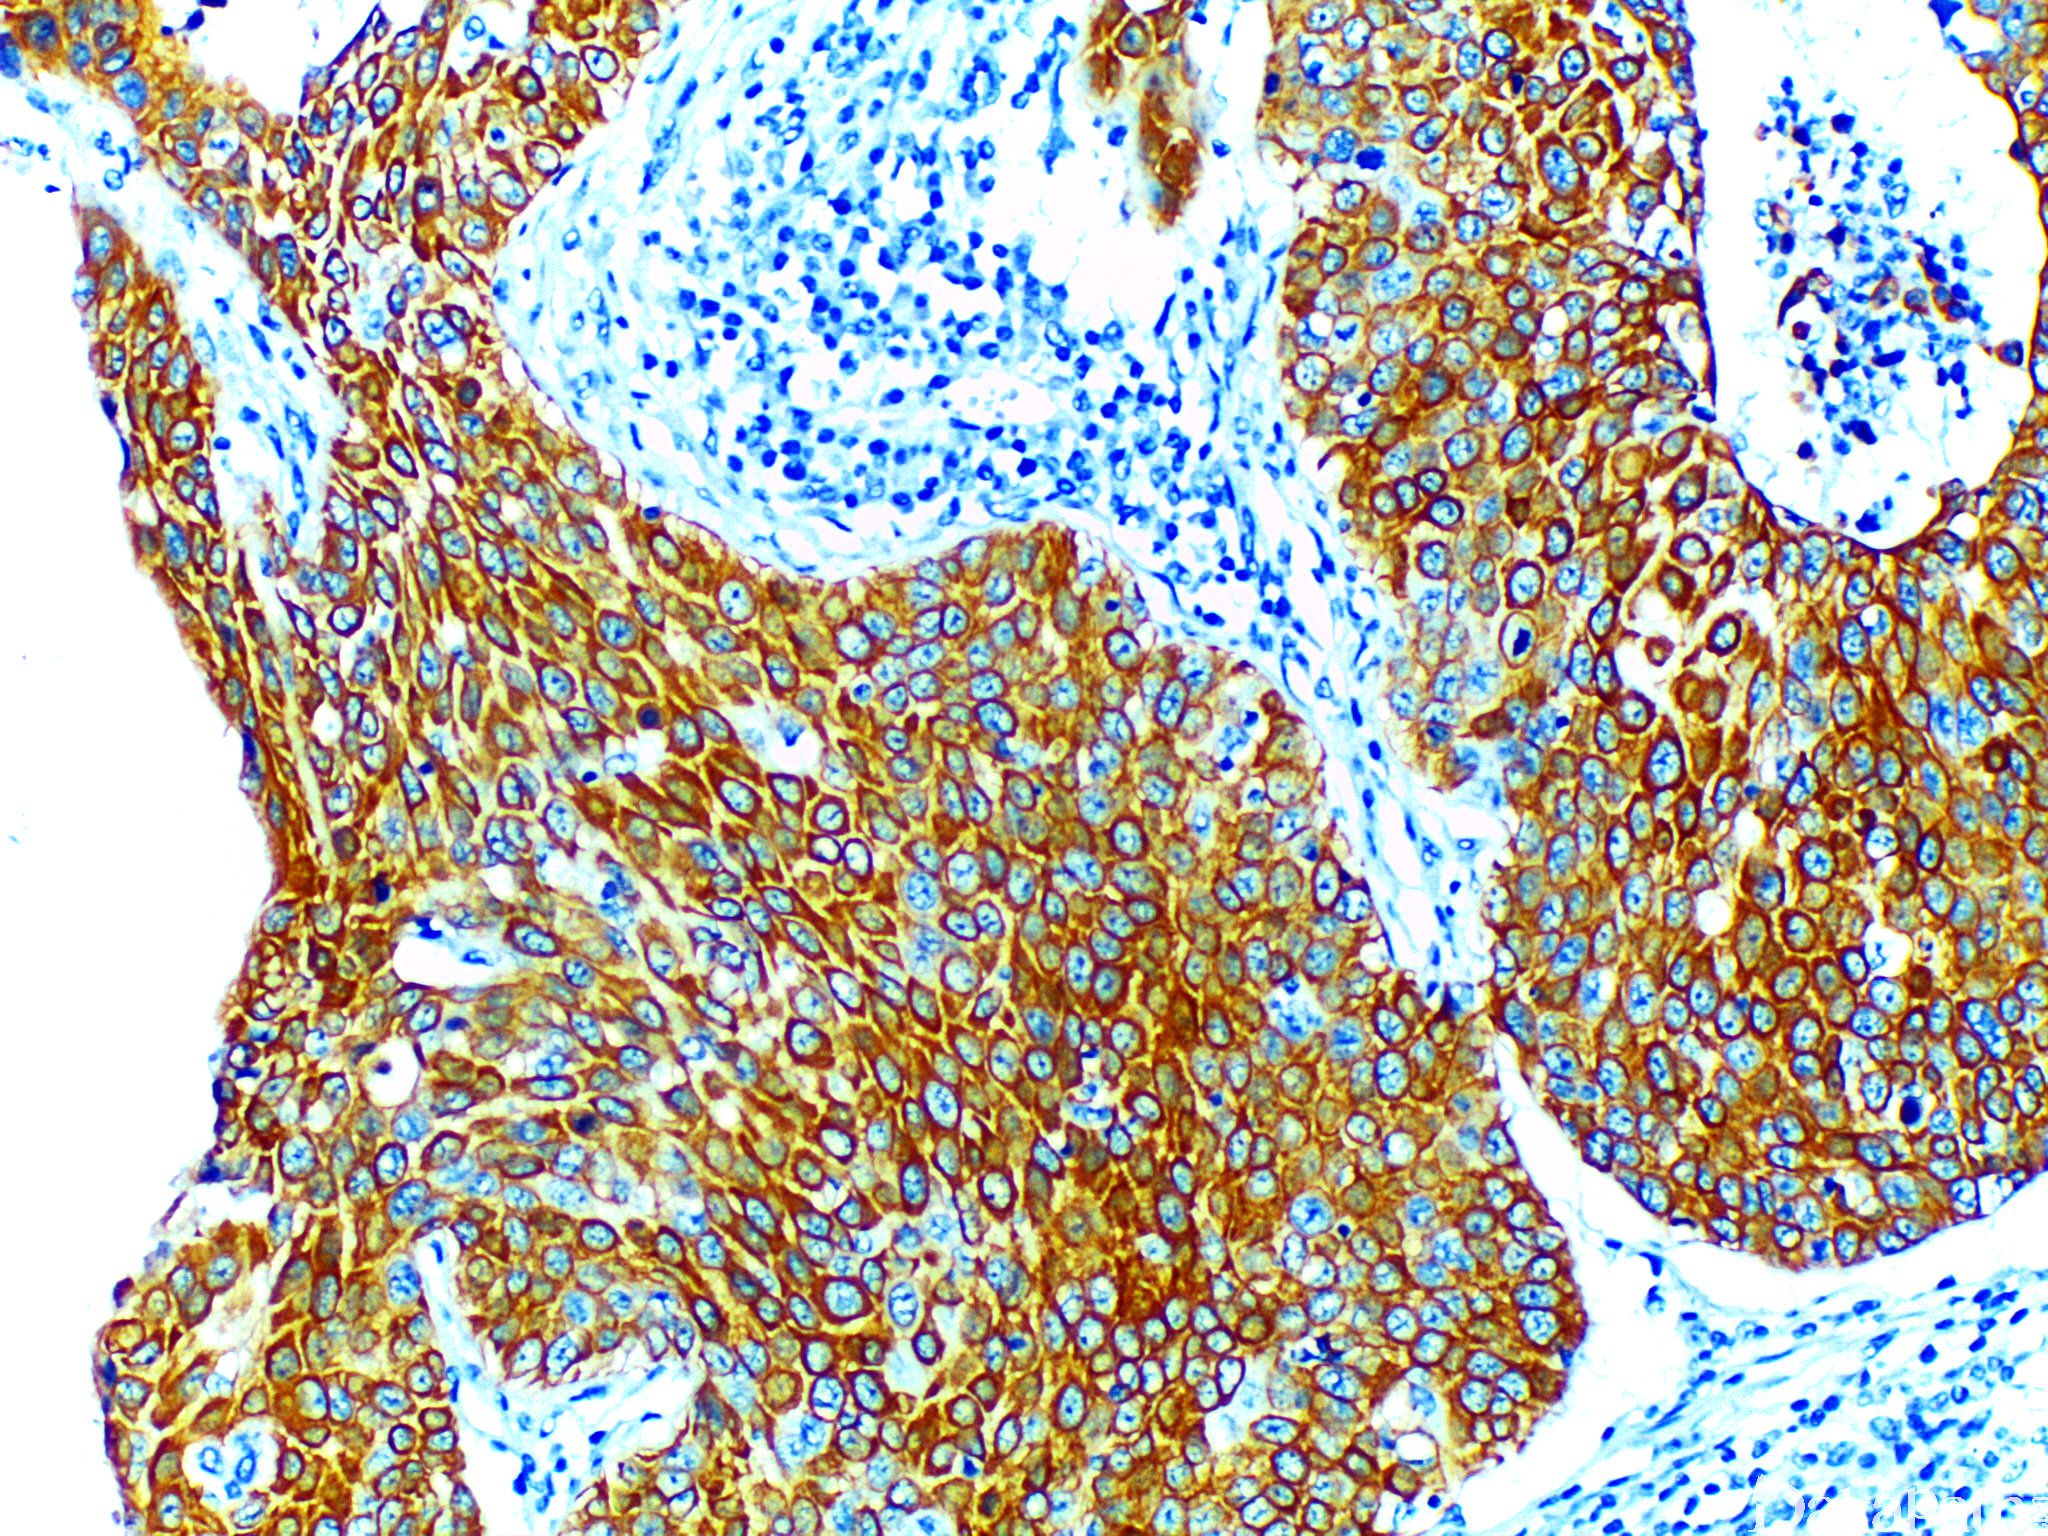

CK5

别名: K5
概述:
II 型细胞角蛋白,分子量为 58kD,表达于鳞状上皮及腺体的基底细胞。
信号定位: 胞质
在病理学中的应用:
乳腺导管原位癌局灶浸润的识别;
乳腺导管增生与实性乳头状癌的鉴别;
乳腺管内癌的分型;
上皮型间皮瘤与肺腺癌的鉴别。
商品化试剂(排名不分先后,本网站对抗体质量不负责!)
公司 | 克隆号 | 即用型(ml) | 原液(ml) | ||||
基因科技 | XM26 | / | 2 | 4 | 7 | / | 0.2 |
赛诺特 | XM26 | 1 | 3 | 6 | / | 0.1 | 0.2 |
EP1601Y | |||||||
中杉金桥 | EP24 | 1.5 | 3 | 6 | / | 0.1 | 0.2 |
安必平 | GM028 | 1.5 | 3 | 6 | / | 0.1 | 0.2 |
在肿瘤中的表达情况:
几乎全部阳性(≥95%的病例阳性): 肺 NUT 癌、乳腺叶状肿瘤,上皮成分、肺腺鳞癌、乳腺乳头状瘤
通常阳性(<95%,≥75%的病例阳性): 上皮样间皮瘤、间皮瘤,NOS、乳腺化生性癌、甲状腺间变性癌、肺鳞状细胞癌、脊索瘤、乳腺囊性高分泌型导管内乳头状癌、乳腺髓样癌
有时阳性(<55%,≥35%的病例阳性): 肺大细胞癌、肺巨细胞癌、腹膜原发性腺癌、上皮样肉瘤、乳腺基底样癌,三阴性
少数阳性(<35%,≥15%的病例阳性): 肺肉瘤样癌、大细胞神经内分泌癌
偶尔阳性(<15%,≥5%的病例阳性): 肺贴壁型腺癌、结直肠黏液性腺癌、乳腺癌,腔 B 型、肺腺癌
几乎全部阴性(<5%的病例阳性): 肾细胞癌、肺透明细胞癌、软骨肉瘤、乳腺浸润性微乳头状癌、骨外黏液性软骨肉瘤、纤维瘤病、乳腺浸润性癌,非特殊类型、肺贴壁型腺癌,黏液性、乳腺癌,腔 A 型、胃腺癌、乳腺浸润性小叶癌、乳腺叶状肿瘤,梭形细胞成分
